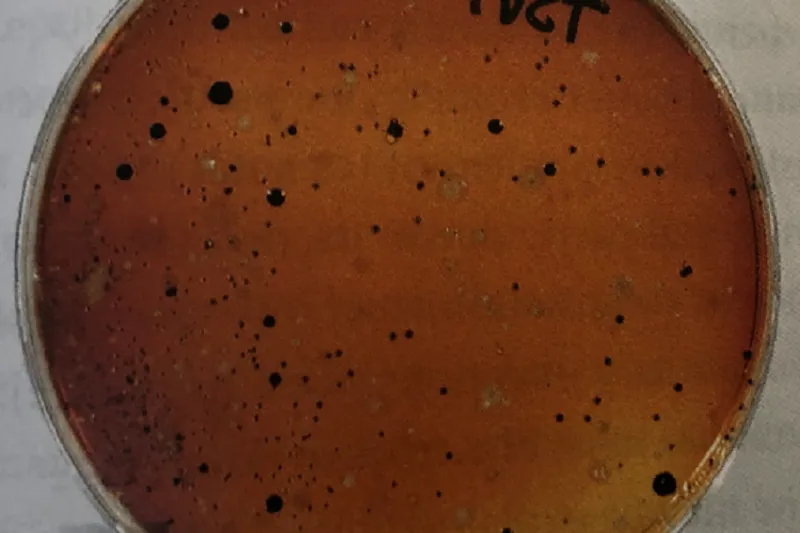

Mikrobiologisk diagnostik forbedrer ikke effekt af antibiotika ved parodontitis
Hvilken effekt har det, at antibiotika bliver anvendt mere specifikt efter forudgående mikrobiologisk diagnostik? Ikke den store mener international forskergruppe, som har udarbejdet en systematisk oversigt over forskningen på området.
Brugen af antibiotika i forbindelse med parodontalbehandling er reduceret kraftigt, især på grund af de alvorlige problemer med udvikling af resistente bakteriestammer.
Men hvad nu, hvis antibiotika bliver anvendt mere specifikt som en art personlig medicin efter forudgående mikrobiologisk diagnostik?
En international forskergruppe med basis i England har udarbejdet en systematisk oversigt over effekten af systemisk antibiotikabehandling som supplement til non-kirurgisk parodontalbehandling hos patienter med og uden forekomst af Aggregatibacter actinomycetemcomitans (Aa).
Oversigten er baseret på fem randomiserede kontrollerede studier med tilsammen 280 patienter, hvoraf 112 var positive for Aa.
Alle patienter fik foretaget grundig subgingival rensning, halvdelen fik antibiotika, de øvrige placebo, og resultaterne blev opgjort efter 6-12 måneder.
De anvendte antibiotika var i fire af undersøgelserne metronidazol og amoxicillin, mens der i det sidste studie blev ordineret moxifloxacin.
Resultaterne viste, at der var lidt større kliniske forbedringer (pochereduktion, fæstegevinst) hos patienter, der havde fået supplerende antibiotikabehandling; men resultaterne var ikke bedre hos de patienter, der var positive for Aa, end hos dem, der var Aa-negative.
Forskerne efterlyser mere forskning inden for emnet personlig antimikrobiel behandling og konkluderer, at det på det foreliggende grundlag ikke kan anbefales at basere brug af antibiotika i parodontalbehandling på mikrobiologiske undersøgelser.
LEKTOR, DR.ODONT. ELLEN FRANDSEN LAU
Institut for Odontologi og Oral Sundhed, Aarhus Universitet
– Forfatterne har givet sig selv en vanskelig opgave.
Ingen studier var designet til at besvare spørgsmålet for den systematiske litteratursøgning, og kun fem levede op til inklusionskriterierne.
At antibiotika giver lidt bedre klinisk behandlingsresultat, er vist utallige gange, men desværre kun med kort tids followup som i de fem inkluderede studier.
Antibiotika kan kun være berettiget, hvis det forbedrer behandlingsresultatet over en meget længere tidshorisont, da konsekvensen ellers er gentagen brug af antibiotika med forøget risiko for resistensudvikling.
At det kliniske behandlingsresultat ikke var bedre hos de Aa-positive patienter end hos Aa-negative, er også forventeligt. Med den rigdom af bakteriearter, der findes i parodontale pocher, vil det være usandsynligt, at en enkelt art kan være indikator for, om antibiotika gavner behandlingen eller ej.
Parodontitis skal fortsat behandles mekanisk som førstevalg. Antibiotika kan kun overvejes, hvis mekanisk behandling fejler hos en patient, der har god mundhygiejne.
Mikrobiologisk prøvetagning bør foretages, hvis der på empirisk vis er givet antibiotika tidligere.
Nibali L, Koidu VP, Hamborg T et al. Empirical or microbiologically guided systemic antimicrobials as adjuncts to non-surgical periodontal therapy? A systematic review. J Clin Periodontol 2019;46:999-1012.